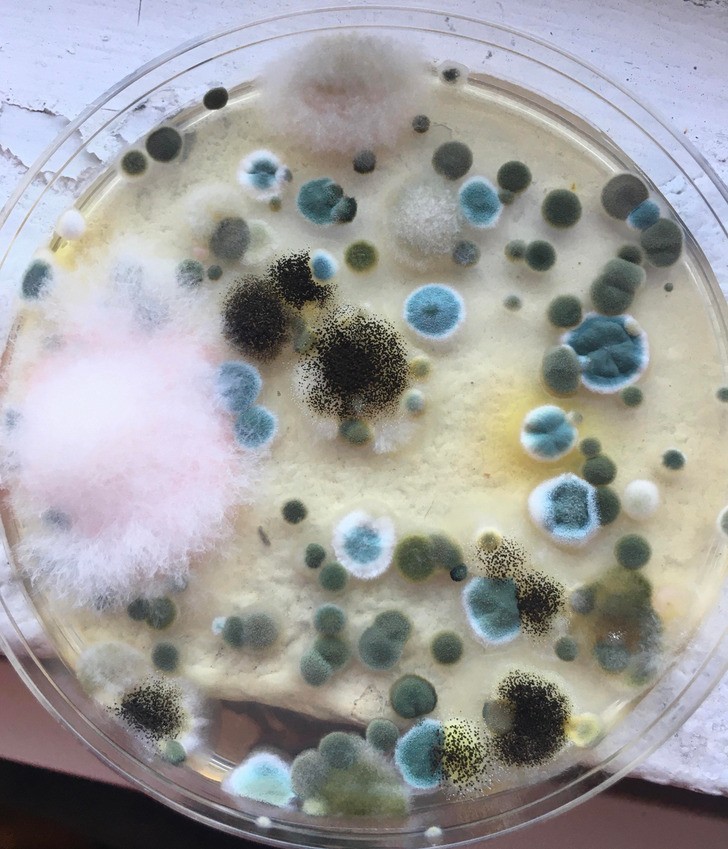

30 разів, коли успіх повернувся до людей спиною (31 фото)
Ніхто не застрахований від невдач, тим більше дрібних неприємностей, які не те щоб сильно псують життя, але неприємний осад залишається. Але чи то страшна катастрофа, чи дрібний прикрий промах, інтернет - відмінне місце, щоб поскаржитися на своє невдачу. 
1. "Мій приятель вирішив, що сонцезахисний стик - хороша ідея" 
2. "Моя нога після того, як я 10 годин проходив у мокрому черевику з діркою" 
3. "Мені прийшли права сьогодні" 
4. "Я сиділа на кришці унітазу в очікуванні, поки наповниться ванна, копалася в телефоні, і тут кришка піді мною розбилася, і я упустила телефон у ванну" 
5. "Мій фудтрак згорів минулого місяця" 
6. "Собака мого сусіда знайшла один із моїх AirPods" 
7. "Позичив братові на день машину, і як подяка він заправив її не тим паливом" 
8. "Я провів тест на плісняву у своїй квартирі"
9. "Пішов у туалет в гостях у друга - трохи інфаркт не вистачив" 
10. "На роботі нам готують їжу перед кожною зміною. Знайомтеся, хот-дог у кабачку" 
11. "Я упустив телефон, і тепер всі фотографії виходять з блакитним відтінком" 
12. "Попросив дружину підрівняти мені потилицю. Так, ми все ще одружені" 
13. "Впустив банку тунця в раковину"
14. "Закрив машину і, мабуть, упустив ключі. Коли повернувся і побачив це: «Я знайшов твої ключі! Якщо хочеш їх одержати, доведеться заплатити!» 
15. "Це я в ортопедичному черевику на зламану ногу на 7-й день із 24-денного туру моєї мрії по Великобританії" 
16. "Ой, там походу колдобина" 
17. "Жодної мені піци сьогодні" 
18. "Забув змастити ноги сонцезахисним кремом" 
19. "А я говорив дружині, що коту не потрібні дорогі іграшки. Кіт довів мою правоту" 
20. "Люблю наш новий будинок ... Крім цього"
21. "Водій Uber поставив свій "портативний туалет" у парі сантиметрів від моєї ноги" 
22. Одна з найскладніших ситуацій у житті
23. "Я замкнений у ванній і не можу вийти" 
24. "Моє скло за 330 доларів у порядку, але, млинець, серйозно?!!"
25. "У мій МакРіб [букв. "МакРебришки"] не поклали реберця... Мабуть, теперце просто Мак" 
26. "Невдалий він вибрав день одягнути рюкзак" 
27. "Ось як розбилася моя чашка" 
28. "Окрім дітей, що кричать, мені ще дісталися ноги" 
29. "Знайшов лапку коника в замороженому гороху після того, як ми вже з'їли половину пакета" 
30. "Відкрив Кіндер-сюрприз, і мені дісталися дві однакові частини однієї іграшки" 










